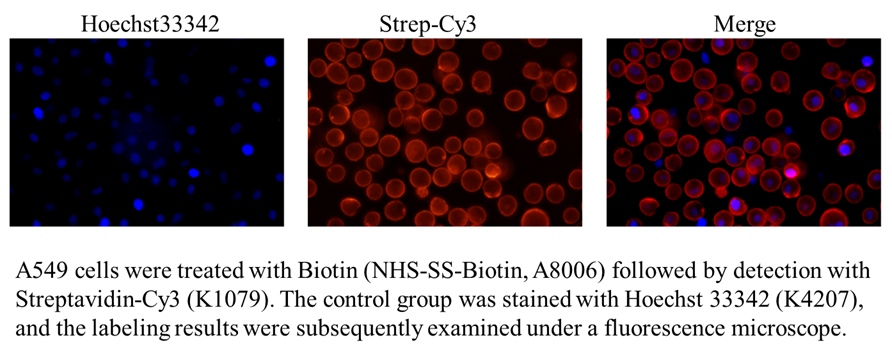

NHS-SS-Biotin
NHS-SS-biotin (Succinimidyl-2-(biotinamido)-ethyl-1,3-dithiopropionate) is a long-chain cleavable amine-reactive biotinylation reagent that has a spacer arm of 24.3 A in length due to the existence of a cross-bridge within its chemical structure. The long spacer arm creates an increased length between a covalently modified molecule and the bicyclic biotin rings that greatly enhances the ability of the molecule to bind to avidin or streptavidin probes. The NHS ester group of NHS-SS-biotin reacts with the amine groups of proteins and other molecule forming an amide bond and releasing of sulfo-NHS. NHS-SS-Biotin is a water-insoluble molecule that requires the dissolution of organic solvents prior to be added to aqueous reactions.
Reference
Bioconjugate Techniques , 2nd ed. By Greg T.Hermanson (Pierce Biotechnology, Thermo Fisher Scientific, Rockford, IL). Academic Press (an imprint of Elsevier): London, Amsterdam, Burlington, San Diego . 2008. ISBN 978-0-12-370501-3.
- 1. Patrick Needham, Richard C Page, et al. "Phage-layer interferometry: a companion diagnostic for phage therapy and a bacterial testing platform." Sci Rep. 2024 Mar 12;14(1):6026 PMID: 38472239
- 2. Xuehui Liu, Zhiyou Zong, et al. "Stimuli‐Mediated Specific Isolation of Exosomes from Blood Plasma for High‐Throughput Profiling of Cancer Biomarkers." Small Methods. 2022 Feb;6(2):e2101234. PMID: 35174989
• Protein labeling—biotinylate antibodies or other proteins for detection or purification using streptavidin probes or resins
• Intracellular labeling—membrane-permeable, can be used to label inside cells
• Amine-reactive—reacts with primary amines (-NH2), such as the side-chain of lysines (K) or the N-terminal-amine
• Cleavable—disulfide bond in spacer arm allows the biotin label to be removed using reducing agents such as DTT
• Solubility—water insoluble, must be dissolved in DMSO or DMF before further dilution in aqueous buffers
• Medium length—spacer arm is 24.3 angstroms; it consists of the native biotin valeric acid group extended by a 7-atom chain
Storage | Store at -20°CThe product is not stable in solution, please dissolve it immediately before use. |
M.Wt | 504.64 |
Cas No. | 122266-55-1 |
Formula | C19H28N4O6S3 |
Synonyms | NHS-SS-Biotin,Biotin disulfide N-hydroxysuccinimide ester |
Solubility | ≥28.79 mg/mL in DMSO; insoluble in H2O; insoluble in EtOH |
Chemical Name | 2,5-dioxopyrrolidin-1-yl 3-((2-(5-((3aS,4S,6aR)-2-oxohexahydro-1H-thieno[3,4-d]imidazol-4-yl)pentanamido)ethyl)disulfanyl)propanoate |
SDF | Download SDF |
Canonical SMILES | O=C1CCC(N1OC(CCSSCCNC(CCCC[C@@H]2SC[C@@](N3)([H])[C@]2([H])NC3=O)=O)=O)=O |
Shipping Condition | Small Molecules with Blue Ice, Modified Nucleotides with Dry Ice. |
General tips | We do not recommend long-term storage for the solution, please use it up soon. |
Biotinylation method [1]: | |
Sample |
hippocampal neurons |
Preparation method |
Soluble in DMSO or DMF. |
Reaction Conditions |
1.5 mg/ml, 4 ℃ for 1 h |
Applications |
Neurons were washed with the artificial cerebrospinal fluid(ACSF) at 37 ℃, and incubated with 1.5 ml of 1.5 mg/ml NHS-SS-biotin with gentle shaking at 4 ℃ for 1 h. After washing, neurons were switched to the neuronal culture medium and incubated at 37 ℃. At indicated times of incubation, neurons were cooled to 4 ℃ and un-endocytosed surface biotin was cleaved by incubating in the glutathione cleavage buffer (50 mM glutathione, 75 mM NaCl, 10 mM EDTA, 1% BSA, and 0.075 N NaOH). Neurons were lysed in the modified RIPA buffer (50 mM Tris–HCl, 150 mM NaCl, 1% NP-40, 0.5% sodium deoxylate, 1 mM EDTA, and protease inhibitors). Lysates were cleared by centrifugation at 10,000g for 10 min at 4 ℃ and incubated at 4 ℃ over-night with 70 μl of 50% streptavidin beads. Endocytosis of ErbB proteins was assayed using cleavable biotin. Bead-associated proteins were subjected to Western blot analysis. |
References: [1]. Yu Liu, Yan-Mei Tao, Ran-Sook Woo, Wen-Cheng Xiong, Lin Mei. Stimulated ErbB4 internalization is necessary for neuregulin signaling in neurons. Biochemical and Biophysical Research Communications 354 (2007) 505–510. |
Description | NHS-SS-Biotin is a cell-permeable and amine-reactive biotinylation reagent. | |||||
Targets | proteins | |||||
IC50 |
Quality Control & MSDS
- View current batch:
Chemical structure

Related Biological Data

Related Biological Data